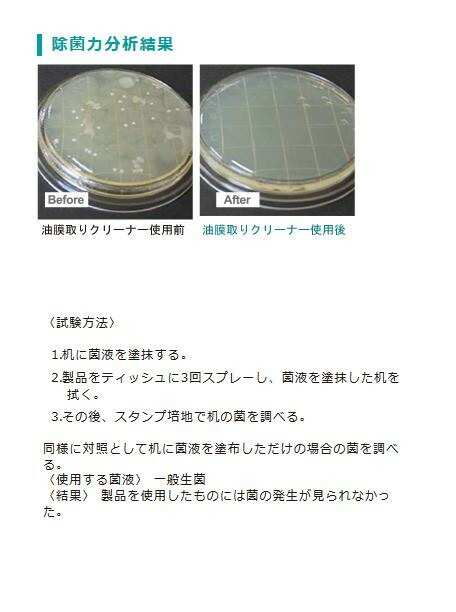
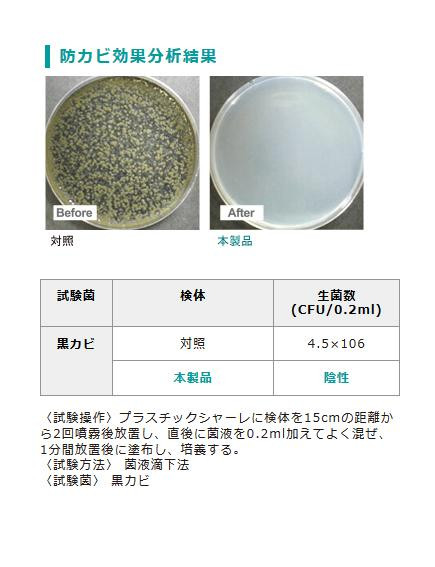

除菌油膜取り洗剤 バリアス油膜取りクリーナー4L 23020032 4981390501031
Pontaパス特典
サンキュー配送
7,880円(税込)
0ポイント(1%)
商品説明
| 油膜取りクリーナー |

|
油膜や手垢で汚れている様々な場所で手軽に除菌できる油膜取りクリーナー。対象面に拭きあとが残りにくく、油膜や手垢、ホコリなどの汚れを落とします。 |
fk094igrjs

| 油膜や手垢で汚れている様々な場所で手軽に除菌できる油膜取りクリーナー。対象面に拭きあとが残りにくく、油膜や手垢、ホコリなどの汚れを落とします。 |
| 内容量 | 4L |
| サイズ | 個装サイズ:30×15×30cm |
| 重量 | 個装重量:4000g |
| 生産国 | 日本 |
除菌油膜取り洗剤 バリアス油膜取りクリーナー4L 23020032 4981390502007
レビュー
商品の評価:



 -点(0件)
-点(0件)
お店の情報
当店の納品書・領収書はダウンロード式になります。
お店の評価:



 -点(0件)
-点(0件)
連絡・応対
-
配送スピード
-
梱包
-